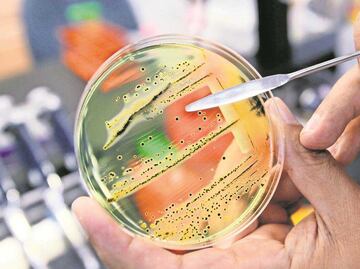

Más Información
¿Alguna vez imaginaste que amar sería doloroso para el cuerpo?. “ La enfermedad del beso ”, también denominada como mononucleosis infecciosa (virus de Epstein-Barr ), es un padecimiento que se trasmite a través de la saliva, ya sea por medio de un beso o a través del contacto con los utensilios usados por la persona infectada, como los vasos. ¿Pero… de qué se trata?
La mononucleosis infecciosa es una enfermedad que no es tan contagiosa como los resfriados . En su página oficial, la clínica mayo informa que las altas probabilidades de contagio de este padecimiento se dan mayormente durante la adolescencia y la adultez, aunque en los niños también puede presentarse sin ningún síntoma.
La transmisión de la “enfermedad del beso” o del virus Epstein-Barr se da mediante el intercambio de saliva, de ahí el nombre de la infección, lo que indica la cercanía entre las personas. Otras formas de infección son a través de la sangre, los líquidos corporales, como el semen, los trasplantes de órganos y la transfusión de sangre.
Lee también:
De acuerdo con el Centro para el Control y la prevención de enfermedades ( CDC ), la enfermedad causa síntomas, como la fatiga extrema, fiebre, dolor de garganta, de cabeza, dolores en el cuerpo, inflamación del hígado o del bazo (órgano que combate infecciones y mantiene el equilibrio de los líquidos del cuerpo), así como de los ganglios linfáticos (cuello, axilas), y sarpullido.
La sintomatología de la enfermedad puede presentarse entre las cuatro y seis semanas posteriores al contagio. Por otra parte, los signos del padecimiento llegan a aparecer lentamente y no todos al mismo tiempo.
En el caso del agrandamiento del bazo y la inflamación del hígado son síntomas no tan comunes.
Lee también:
¿Cómo prevenir la enfermedad del beso?
Si bien la CDC reporta que no existen vacunas para contrarrestar los efectos de la enfermedad, se recomienda no compartir artículos de uso personal, como los cepillos de dientes, con una persona infectada. Por otra parte, evitar compartir bebidas.
¿Qué medicamentos no tomar cuando padeces mononucleosis infecciosa?
El portal refiere que, de acuerdo con la gravedad de los síntomas, el especialista tiene que establecer el tratamiento adecuado para el paciente; sin embargo, no se recomienda tomar ampicilina o amoxicilina.
Noticias según tus intereses
[Publicidad]
[Publicidad]